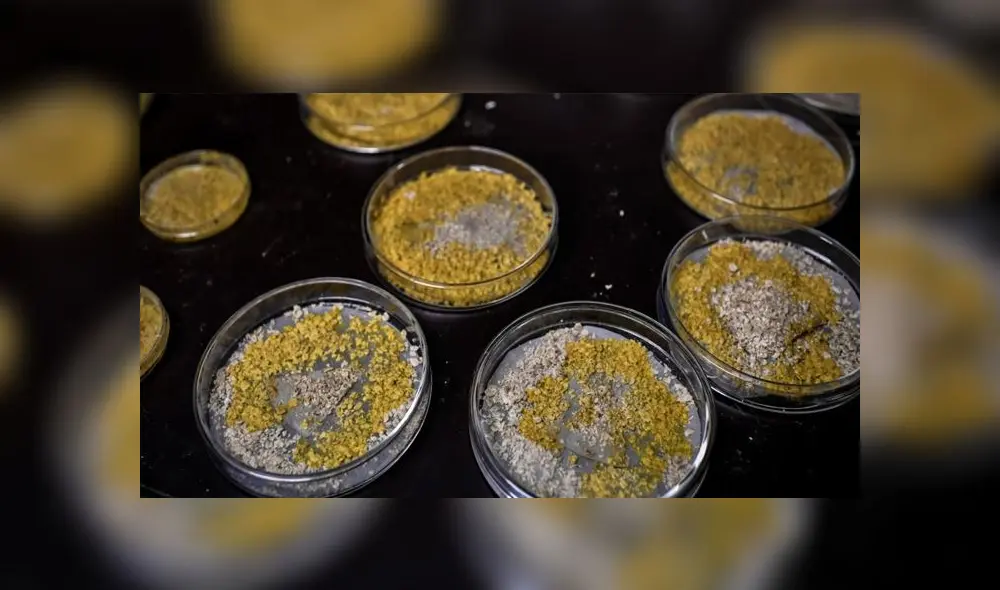
“Podemos crear 'Blobs' de todos los tamaños, no hay un límite conocido”, enfatizó una científica francesa. Foto: AFP “Podemos crear 'Blobs' de todos los tamaños, no hay un límite conocido”, enfatizó una científica francesa. Foto: AFP

La extraña criatura que posee 720 sexos, puede regenerarse y aprender pese a no tener cerebro [FOTOS]
‘Blob’ es catalogado como uno de los misterios de la naturaleza, debido a que apareció hace 500 millones de años y posee características nunca antes vistas por los científicos. El zoológico de París exhibirá esta fascinante especie.
- China intensifica tensiones con un país de América Latina y advierte que pagará un precio muy alto por anular contrato comercial
- EE. UU. sancionará con arancel adicional del 25% a países que mantengan relaciones comerciales con Irán
Un hito de la ciencia. El zoológico de París exhibirá a ‘Blob’, una extraña criatura que posee 720 sexos, puede regenerarse y crecer hasta 10 metros a pesar de no poseer un cerebro.
Las sorprendentes habilidades de esta especie fueron estudiadas por el Centro de Investigación en Cognición Animal de Toulouse, quienes descubrieron su capacidad para trasmitir el conocimiento a otros mohos, algo impensado para tratarse de un .organismo de los fangos.
TE RECOMENDAMOS
PAJERÍGATE: VISITAS NOCTURNAS A PALACIO Y CONTRATOS MILLONARIOS |LA VERDAD A FONDO CON PEDRO SALINAS
PUEDES VER Agujeros negros: cómo nacen, por qué devoran todo y qué enigma guardan sobre el origen del universo
«Nos sorprende porque no tiene cerebro, pero es capaz de aprender (...) y si fusionas dos, el que ha aprendido transmitirá su conocimiento al otro», cuenta a los medios locales, Bruno David, director del Museo de Historia Natural de París, entidad que regula al zoológico donde expondrán a ‘Blob’.
Cabe resaltar que el particular moho fue bautizado como ‘Blob’ en honor a una película de 1959 protagonizada por Steve McQueen, en la que una ameba gigante alienígena devora una comunidad de Pennsylvania, Estados Unidos.
“Ni animal, ni planta, ni hongo, es un organismo primitivo, apareció hace 500 millones de años, antes del reino animal. No está claro dónde colocarlo en el árbol de la vida”, enfatiza la autoridad científica sobre ‘Blob’, que también puede detectar alimentos y digerirlos, aunque no tenga boca.
Este espécimen de tonalidad amarillenta y familiarizada con los Physarum polycephalum (mohos de varias cabezas), puede crecer en un laboratorio o en los residuos forestales. Además, tarda aproximadamente dos minutos para que las partes fraccionadas puedan seguir con su flujo a pesar de no contar con extremidades que le permitan ir de un lugar a otro.
“Podemos crear ‘Blobs’ de todos los tamaños, no hay un límite conocido”, contó a AFP, Audrey Dussutour, científica del Centro Nacional para la Investigación Científica de Francia.

![La extraña criatura que posee 720 sexos, puede regenerarse y aprender pese a no tener cerebro [FOTOS] La extraña criatura que posee 720 sexos, puede regenerarse y aprender pese a no tener cerebro [FOTOS]](https://imgmedia.larepublica.pe/1000x590/larepublica/migration/images/PLITJ4VE5ZDXNCIK6L77F4CO3U.webp)
![La extraña criatura que posee 720 sexos, puede regenerarse y aprender pese a no tener cerebro [FOTOS] La extraña criatura que posee 720 sexos, puede regenerarse y aprender pese a no tener cerebro [FOTOS]](https://imgmedia.larepublica.pe/1000x590/larepublica/migration/images/QRA6JZRMZNDMRHLCBDTJIEXITE.webp)

















